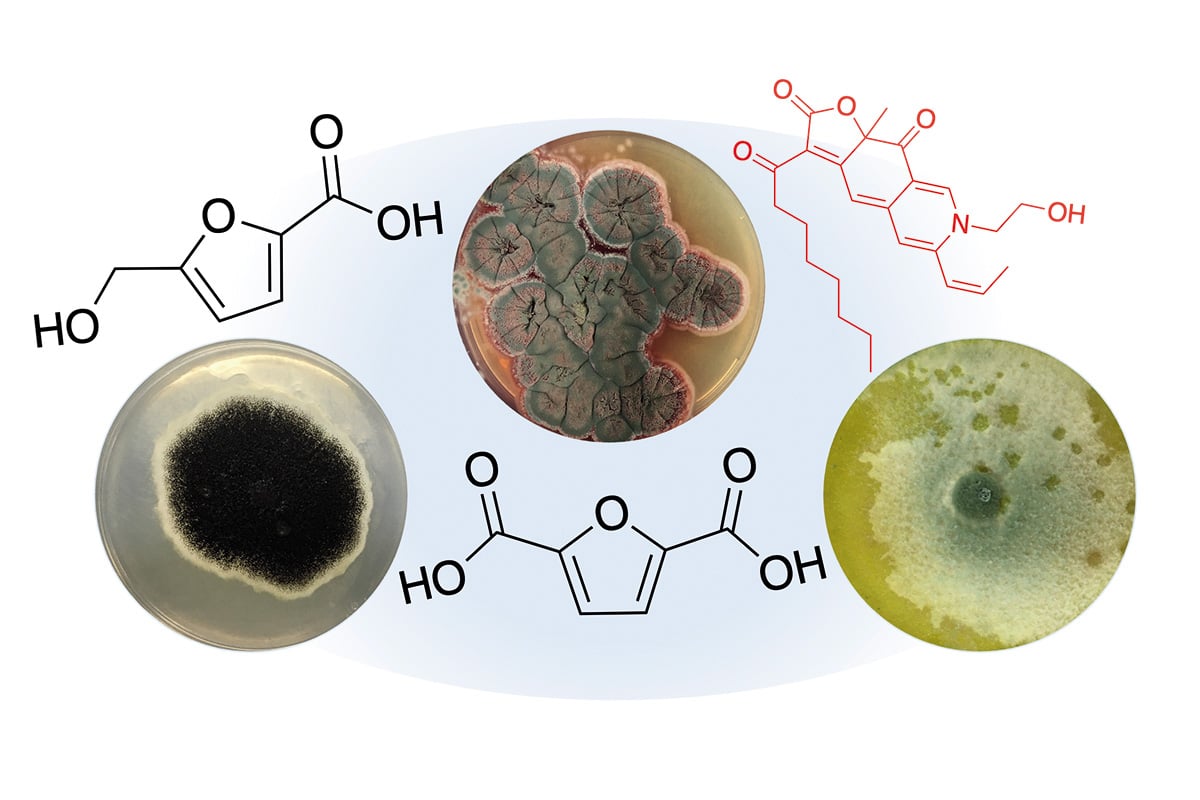

En haut, de gauche à droite : les champignons Aspergillus niger, Penicillium purpurogenum et Trichoderma reesei avec les représentations moléculaires des pigments et des molécules chimiques qu’ils produisent.
Accepteriez-vous de manger des bonbons, des glaces ou des pâtisseries dont les couleurs vibrantes auraient été extraites… de restes de table ? Des chimistes mettent au point les couleurs de demain.
En observant la rangée de fioles contenant des liquides aux teintes rouges, jaunes et orangées produits par le doctorant Derek Troiano de l’Université McGill, on croirait se trouver devant des colorants alimentaires vendus en supermarché. Or ils sont le fruit d’un procédé peu appétissant, mais ô combien innovant : la fermentation de déchets alimentaires par des champignons microscopiques.
Ces biopigments nouveau genre offrent le potentiel de réduire notre dépendance à l’industrie pétrochimique pour colorer aliments et autres produits de consommation tout en valorisant une ressource négligée depuis longtemps. « Notre objectif, c’est de réduire la quantité de matière organique qui va vers l’enfouissement ou le compostage, explique Valérie Orsat, professeure de chimie à l’Université McGill et coauteure d’une étude sur le sujet parue en mai dernier dans la revue Applied Microbiology and Biotechnology . On veut en maximiser la réutilisation et lui donner une valeur commerciale tout en réduisant notre impact environnemental. »
Trognons de pomme, bouts de céleri, pelures de betteraves : comment produire des couleurs à partir d’un tel fatras ? Les scientifiques se sont inspirés d’une technique ancestrale employant un champignon filamenteux microscopique nommé Monascus .







